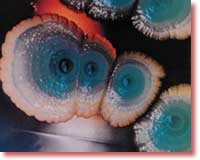

İMMUNİTET, “RUDİMENT ORQANLAR”
VƏ EMBRİOLOGİYA
Əvvəlki bölmələrdə təkamül nəzəriyyəsinin paleontologiya və molekulyar biologiya sahələrində qarşılaşdığı ziddiyyətləri və düşdüyü çıxılmaz vəziyyətləri elmi dəlillər və kəşflər əsasında təhlil etdik. Bu bölmədə isə təkamülçü mənbələrdə nəzəriyyəyə dəlil kimi göstərilən bəzi bioloji faktlardan bəhs edəcəyik. Bu faktlar əslində təkamül nəzəriyyəsini dəstəkləyən heç bir elmi kəşfin olmadığını göstərir.
Bakteriyaların antibiotiklərə qarşı müqaviməti Təkamülçülərin nəzəriyyələrinə dəlil kimi göstərməyə çalışdıqları bioloji faktlardan biri bakteriyaların antibiotiklərə qarşı müqavimətidir. Təkamül nəzəriyyəsini dəstəkləyən bir çox mənbə antibiotiklərə qarşı müqaviməti “faydalı mutasiyaların canlıları təkmilləşdirdiyinə nümunə” kimi göstərir. Buna bənzər bir iddia DDT kimi dərman vasitələrinə qarşı immunitet qazanan həşəratlar haqqında da irəli sürülür.
Halbuki bu məsələdə də təkamülçülər yanılırlar.
Antibiotiklər bəzi mikroorqanizmlər tərəfindən digər mikroorqanizmlərə qarşı mübarizə aparmaq üçün hazırlanan “öldürücü molekullardır”. İlk antibiotik 1928-ci ildə Aleksandr Fleminq tərəfindən kəşf edilən penisilindir. Fleminq kif göbələyinin stafilakokk (Staphylococcus) bakteriyasını öldürən molekul hazırladığını aşkar etmiş və bu kəşf tibb dünyasında yeni cığır açmışdır. Mikroorqanizmlərdən götürülən antibiotiklər müxtəlif bakteriyalara qarşı istifadə edilmiş və uğurlu nəticələr əldə edilmişdir. Ancaq bir müddət sonra məlum olmuşdur ki, bakteriyalar antibiotiklərə qarşı zaman ərzində immunitet qazanırlar. Bunun mexanizmi isə belə işləyir: antibiotikə məruz qalan bakteriyaların böyük hissəsi ölür, amma bəziləri bu antibiotikdən təsirlənmir və bunlar sürətlə çoxalaraq bütöv populyasiya əmələ gətirirlər. Beləliklə, bütün populyasiya antibiotikə qarşı müqavimətlı olur.
Təkamülçülər isə bu faktı “bakteriyaların şərtlərə uyğunlaşaraq təkamül keçirməsi” kimi göstərməyə cəhd edirlər.
Halbuki məsələ bu səthi təkamülçü dəyərləndirmədən çox fərqlidir. Bu mövzuda ən ətraflı elmi fəaliyyət göstərən şəxslərdən biri 1997-ci ildə nəşr olunmuş “Təsadüfən deyil” (Not by chance) adlı kitabı ilə tanınan israilli biofizik prof. Li Spetnerdir. Spetner bakteriya immunitetinin iki fərqli mexanizmlə təmin edildiyini, amma bunların ikisinin də təkamül nəzəriyyəsinə heç bir dəlil olmadığını izah edir. Bu iki mexanizm:
1)Bakteriyalarda əvvəlcədən mövcud olan müqavimət genlərinin ötürülməsi və,
2)Mutasiya nəticəsində genetik məlumat itkisinə uğrayan bakteriyaların antibiotikə qarşı müqavimət qazanmasıdır.
Spetner 2001-ci il tarixli bir məqaləsində ilk mexanizmi belə izah edir:
Bəzi mikroorqanizmlər antibiotiklərə müqavimət göstərən genlərə malikdirlər. Bu immunitet antibiotik molekulunun formasını pozma və ya onu hüceyrədən kənara atma sayəsində baş verir. Bu genlərə malik olan orqanizmlər bunu digər bakteriyalara ötürərək onlara da immunitet qazandıra bilirlər. İmmunitet mexanizmi müəyyən antibiotikə istiqamətlənsə də, bir çox patogenik bakteriya fərqli gen dəstləri qazanır.
Prof. Spetner bunun “təkamülə dəlil” olmadığını isə belə açıqlayır:
Antibiotikə qarşı müqavimətin bu şəkildə əldə edilməsi... təkamül üçün dəlil təşkil etməsi gözlənilən mutasiyalar üçün nümunə deyil. Nəzəriyyəyə (təkamül) dəlil göstərilən mutasiyalar bakteriyanın genomuna məlumat əlavə edən genetik dəyişikliklər deyil, bu dəyişikliklər eyni zamanda bütün biokosma (bioloji aləmə) məlumat əlavə etməlidir. Genlərin üfüqi ötürülməsi ancaq bəzi növlərdə mövcud olan məlumatı yayır.
Bakteriyalar müqavimət genlərini bir-birlərinə ötürməklə antibiotiklərə qarşı
qısa zamanda immunitet qazanırlar. Yuxarıda E. coli bakteriyalarının əmələ gətirdiyi
populyasiya görünür.
Bakteriyalar müqavimət genlərini bir-birlərinə ötürməklə antibiotiklərə qarşı
qısa zamanda immunitet qazanırlar. Yuxarıda E. coli bakteriyalarının əmələ gətirdiyi
populyasiya görünür.
|
Yəni təkamül yoxdur, çünki yeni genetik məlumat ortaya çıxmır, sadəcə əvvəlcədən mövcud olan bir genetik məlumat bakteriyalar arasında ötürülür.
İmmunitetin ikinci növü, yəni mutasiya nəticəsində üzə çıxan immunitet də təkamülə dəlil deyil. Spetner bu mövzunu belə açıqlayır:
Bəzən də bir mikroorqanizm bircə nukleotidin (DNT pilləsinin) təsadüfən yerini dəyişdirməsi nəticəsində antibiotikə qarşı immunitet qazanır... Məsələn, ilk dəfə Uoksman və Albert Şatz tərəfindən kəşf edilən, 1944-cü ildə xəbər verilən Streptomisin (Streptomycin) bakteriyaların bu yolla immunitet qazandığı bir bakteriyadır. Amma keçirdikləri mutasiya Streptomisin üçün yararlı olsa da, yenə də bu neo-darvinist nəzəriyyənin ehtiyacı olan mutasiya növü deyil. Streptomisinə immunitet qazandıran mutasiyanın təsiri ribosomda ortaya çıxır və bu mutasiya antibiotik molekulu ilə ribosom arasındakı molekulyar cütləşməni pozur.
Spetner bu hadisəni “Təsadüfən deyil” (Not by chance) adlı kitabında qıfıl-açar əlaqəsinin pozulmasına bənzədir. Streptomisin bir qıfıla tamamilə uyğun gələn bir açar kimi bakteriyaların ribosomuna yapışır və bu ribosomu təsirsiz hala salır. Mutasiya isə ribosomun formasını pozur və bu təqdirdə Streptomisin ribosoma yapışa bilmir. Bu, “bakteriya streptomisinə qarşı immunitet qazandı” kimi izah edilsə də, əslində bakteriya üçün qazanc deyil, itkidir. Spetner sözünə belə davam edir:
Məlum olur ki, (ribosomun quruluşundakı) bu pozulma bir xüsusiyyətin azalması, yəni bir məlumat itkisidir. İş də burasındadır ki, (təkamül) bu cür mutasiyalarla baş vermir, bu mutasiyalar nə qədər çox olsa da. Təkamülün xüsusiyyəti azaldan mutasiyalarla baş verməsi mümkün deyil...
Mövzunun xülasəsi belədir: bakteriyanın ribosomuna təsir edən bir mutasiya bu bakteriyanı streptomisinə qarşı müqavimətli edir. Amma bunun səbəbi mutasiyanın ribosomu “pozmasıdır”. Yəni bakteriyaya genetik məlumat əlavə edilmir. Əksinə, ribosomun forması pozulur, əslində bir növ bakteriya “şikəst” olur. (Belə ki, bu mutasiyanı keçirən bakteriyaların ribosomunun normal bakteriyalara nisbətən daha faydasız olduğu müəyyən edilmişdir). Bu “şikəstlik” ribosoma yapışacaq quruluşa malik olan antibiotikə mane olduğu üçün “antibiotikə qarşı müqavimət” əmələ gəlir.
Nəticədə ortaya “genetik məlumatı təkmilləşdirən” mutasiya nümunəsi çıxmır. Antibiotikə qarşı müqaviməti təkamülə dəlil kimi göstərmək istəyən təkamülçülər mövzunu çox səthi şəkildə dəyərləndirir və yanılırlar.
Eyni vəziyyət DDT və buna bənzər kimyəvi maddələrə qarşı həşəratlarda əmələ gələn immunitetə də aiddir. Bu immunitet nümunələrinin çoxunda əvvəlcədən mövcud olan immunitet genlərindən istifadə edilir. Təkamülçü bioloq Fransisko Ayala “Həşərat zəhərlərinin ən təsirli növlərinə qarşı immunitet bu süni maddələr həşəratlara tətbiq edildikdə o həşərat növünün müxtəlif genetik variasiyalarında açıq şəkildə mövcud idi” deyərək bu həqiqəti qəbul edir.Mutasiya ilə açıqlanan digər bəzi nümunələr isə eynilə yuxarıda izah edilən ribosom mutasiyasında olduğu kimi həşəratlarda “genetik məlumat itkisinə” yol açan faktlardır.
Bu halda bakteriya və həşəratlarda immunitet mexanizmlərinn təkamül nəzəriyyəsinə dəlil olduğu irəli sürülə bilməz. Çünki təkamül nəzəriyyəsi canlıların mutasiyalar yolu ilə inkişaf etdiyi iddiasına əsaslanır. Spetner nə antibiotikə qarşı immunitetin, nə də başqa bioloji faktın bu cür mutasiyaya nümunə olmadığını belə açıqlanır:
Makrotəkamülün ehtiyacı olan mutasiyalar heç vaxt müşahidə edilməmişdir. Neodarvinist nəzəriyyənin ehtiyacı olan təsadüfi mutasiyaları təmsil edən, molekulyar səviyyədə təhlil edilmiş heç bir mutasiyanın genetik məlumat əlavə etdiyi müşahidə edilməmişdir. Sual: “müşahidə edilmiş mutasiyalar nəzəriyyəyə dəlil olan mutasiyalardır?” Cavab: “Xeyr”.
Rudiment orqanlar xətası
Təkamülçü ədəbiyyatda uzun müddət yer alan, amma əsassızlığı məlum olduqdan sonra səssiz-sədasız bir kənara qoyulan iddialardan biri də “rudiment orqanlar” anlayışıdır. Ancaq bəzi yerli təkamülçülər “rudiment orqanları” hələ də təkamülün böyük dəlili hesab edir və elə göstərməyə çalışırlar.
Rudiment orqanlar iddiası bundan bir əsr əvvəl irəli sürülmüşdü. İddiaya əsasən, canlıların orqanizmlərində əcdadlarından onlara miras qalmış, ancaq istifadə edilmədiyi üçün zaman ərzində funksiyasını itirmiş orqanlar mövcuddur.
 Rudiment orqanlar əfsanəsinin
əsassızlığı haqqında elmi fəaliyyət:
“Rudiment orqanlar” tam
funksionaldır.
Rudiment orqanlar əfsanəsinin
əsassızlığı haqqında elmi fəaliyyət:
“Rudiment orqanlar” tam
funksionaldır.
|
Bu əsla elmi iddia deyildi, çünki məlumat çatışmazlığından qaynaqlanırdı. “Funksiyasını itirmiş orqanlar” əslində “funksiyası müəyyən edilməmiş” orqanlar idi. Bunun ən yaxşı göstəricisi də təkamülçülər tərəfindən sadalanan uzun “rudiment orqanlar” siyahısının getdikcə qısalması oldu. Özü də bir təkamülçü olan S.R.Skedinq “Təkamül nəzəriyyəsi” (Evolutionary theory) jurnalında dərc etdirdiyi “Rudiment orqanlar təkamülə dəlildirmi?” başlıqlı məqaləsində bu həqiqəti belə qəbul edir:
(Biologiya haqqında) məlumatımız artdıqca rudiment orqanlar siyahısı da getdikcə qısaldı... Bir orqanın funksiyasız olduğunu müəyyən etmək mümkün olmadığına və onsuz da rudiment orqanlar iddiası elmi xüsusiyyət daşımadığına görə, “rudiment orqanların” təkamül nəzəriyyəsi lehinə hər hansı dəlil təşkil etmədiyi nəticəsinə gəlmişəm.
Alman anatomiyaçısı R.Viderşeym tərəfindən 1895-ci ildə ortaya atılan “rudiment insan orqanları” siyahısı appendiks, büzdüm sümüyü kimi təxminən 100 orqandan ibarət idi. (Appendiks, əsasən, “apendisit” kimi tanınan orqandır. Dilimizdə səhvən “appendisit” tələffüz edilən bu söz əslində bu orqanın infeksiyaya uğramasına verilən addır). Ancaq elm inkişaf etdikcə Viderşeymin siyahısındakı orqanların hamısının orqanizmdə çox mühüm funksiya yerinə yetirdiyi məlum oldu. Məsələn, “rudiment orqan” hesab edilən appendiksin əslində orqanizmə daxil olan mikroblara qarşı mübarizə aparan limfa sisteminin bir hissəsi olduğu müəyyən edildi. Bu həqiqət 1997-ci il tarixli bir tibbi mənbədə belə bildirilir:
Orqanizmdəki qalxanabənzər vəz, dalaq, appendiks, sümük iliyi kimi orqanlar limfa sisteminin hissələridir. Onlar da orqanizmin infeksiya ilə mübarizə aparmasına kömək edirlər.
Eyni “rudiment orqanlar” siyahısına daxil edilmiş badamcıqların da boğazı xüsusilə yetkinlik yaşına qədər infeksiyalara qarşı qorumaqda mühüm rol oynadığı məlum oldu. Onurğa sümüyünün son hissəsi olan büzdüm sümüyünün isə çanaq sümüyünün ətrafındakı sümüklərə dəstək olduğu, bu səbəbdən, büzdüm sümüyü olmadan rahat oturmağın mümkün olmadığı məlum oldu. Bundan əlavə, bu sümüyün çanaq hissəsindəki orqanların və buradakı müxtəlif əzələlərin də birləşdiyi sümük olduğu müəyyən edildi.
|
|
Təkamülçü bioloqların “rudiment orqanlar” hesab
etdikləri apendisitin (yuxarıda) immun
sistemində mühüm rolu olduğu məlum olmuşdur. Büzdümsümüyü adlanan onurğanın ən aşağı hissəsi
də “rudiment orqan” deyil,
əzələlərin birləşmə yeridir.
|
Sonrakı illərdə yenə “rudiment orqanlardan” hesab edilən qalxanabənzər vəzin T hüceyrələrini hərəkətə gətirərək orqanizmin limfa sistemini aktivləşdirdiyi, epifiz vəzin lütein hormonuna təsir edən melatonin hormonu ifraz etdiyi kəşf edildi. Tiroid vəzinin körpələrdə və uşaqlarda orqanizmin normal inkişafını təmin etdiyi və maddələr mübadiləsi və orqanizmin aktivliyinin tənzimlənməsində rol oynadığı müəyyən edildi. Hipofiz vəzinin ön payının da tiroid, böyrəküstü vəz, çoxalma vəzləri kimi bir çox hormon vəzinin düzgün fəaliyyət göstərməsini və skeletin inkişafını tənzimlədiyi aşkar edildi.
Darvin tərəfindən “rudiment orqan” adlandırılan gözdəki aypara formasındakı çıxıntının isə gözün təmizlənməsi və nəmləndirilməsində mühüm rol oynadığı məlum oldu.
Rudiment orqanlar iddiasında təkamülçülərin çox mühüm məntiqi səhvi də vardı. Məlum olduğu kimi bəzi təkamülçülər canlılardakı rudiment orqanların keçmişdəki əcdadlarından miras qaldığını iddia edirdilər. Halbuki “rudiment orqan” hesab edilən bəzi orqanlar insanın əcdadı olduğu iddia edilən canlılarda yoxdur! Məsələn, təkamülçülər tərəfindən insanın əcdadı hesab edilən bəzi meymunlarda appendiks yoxdur. Rudiment orqanlar tezisinə qarşı çıxan bioloq H.Enok bu məntiqi səhvi belə ifadə edir:
İnsanların appendiksi var. Ancaq daha qədim əcdadları olan ibtidai meymunlarda appendiks yoxdur. Appendiks təəccüblü şəkildə daha ibtidai quruluşa malik olan məməlilərdə, məsələn, opossumlarda yenidən üzə çıxır. Elə isə təkamül nəzəriyyəsi bunu necə açıqlaya bilər?
Bütün bunlarla bərabər, funksiyasını itirmiş bir orqanın zaman ərzində kiçilərək yox olması məntiqi cəhətdən ziddiyyətlidir. Bu ziddiyyəti dərk edən Darvin “Növlərin mənşəyi” kitabında belə etiraf edir:
Bununla yanaşı, başqa bir çətinlik də var. Bir orqan artıq funksiyasını itirdiyi üçün çox kiçildikdən sonra iz qoyaraq necə kiçilə bilir və nəticədə necə tamamilə yoxa çıxır? Bir orqan bir dəfə funksiyasını itirdikdən sonra istifadəsiz qalmasının həmin orqana müsbət təsiri ola bilməz. Burada mənim verə bilməyəcəyim bir açıqlamaya ehtiyac var.
Qısaca desək, təkamülçülər tərəfindən ortaya atılan rudiment orqanlar ssenarisinin həm öz daxilində məntiqi səhvləri var, həm də elmi cəhətdən səhvdir. İnsanlarda “əcdadlarından miras qalmış” heç bir rudiment orqan yoxdur.
“Rudiment orqanlara” daha bir zərbə: atın ayağı
Rudiment orqanlar nağılına ən son zərbəni atın ayağı üzərində aparılmış bir tədqiqat vurdu. “Təbiət” (Nature) jurnalının 20-27 dekabr 2001-ci il tarixli sayında dərc edilən “Biomexanika: təhlükəli vibrasiyalara qarşı amortizator” (Biomechanics: Damper for bad vibrations) adlı məqalədə belə deyilir:
Atların ayaqlarındakı bəzi əzələ lifləri heç bir funksiyası olmayan təkamül prosesinin qalıqları kimi görünür. Ancaq əslində bu əzələ lifləri at qaçarkən ayağın içində əmələ gələn zərərli titrəmələrin qarşısını alırlar.
Məqalə belə davam edir:
Atların və dəvələrin ayaqlarında 6 millimetrdən daha qısa əzələ liflərinə bağlı olan 600 millimetrdən daha uzun vətərləri olan əzələləri var. Bu cür qısa əzələlər heyvan hərəkət etdikcə uzunluğunu ancaq bir neçə millimetr dəyişdirə bilir və bunlar böyük məməlilərin o qədər də işinə yarayan kimi görünmür. Vətərlər passiv yaylar kimi funksiya yerinə yetirir və qısa əzələ liflərinin lazımsız olduğu təkamül prosesində funksiyasını itirmiş daha uzun liflərin qalıqları olduğu hesab edilmişdir. Ancaq Uilson və həmkarları... bu liflərin sümük və vətərləri potensial şəkildə zərər verən titrəmələrdən qoruduğunu irəli sürürlər...
Təcrübələr qısa əzələ liflərinin bir ayağın yerə vurulmasının ardınca əmələ gələn zərərli titrəmələri yavaşlatdığını göstərmişdir. Qaçan bir heyvan ayağını yerə vurduqda bu zərbə ayağın titrəməsinə səbəb olur, titrəmələrin tezliyi nisbi yüksəkdir. Məsələn, atlarda 30-40 hz – ayaq yerdə ikən bu zərbələr yavaşladılmasa, artıq titrəmə dövranı baş verir.
Titrəmələr zərər verə bilər, çünki sümük və vətərlər yorğunluq vəziyyətindən tez təsirlənirlər. Sümük və vətərlərdəki yorğunluq təkrarən baş verən təzyiqdən qaynaqlanan zərərin toplanmasıdır. Sümük yorğunluğu həm atletlərdə, həm də yarış atlarında mənfi təsirlər meydana gətirən zərbə qırılmalarının səbəbidir və vətər yorğunluğu ən az bəzi vətər infeksiyalarının səbəbi ola bilər. Uilson və həmkarları çox qısa əzələ liflərinin əmələ gələn titrəmələri yavaşladaraq həm sümükləri, həm də vətərləri qoruduğunu irəli sürürlər.
Qısaca desək, atların anatomiyasının daha diqqətlə təhlil edilməsi təkamülçülərin funksiyasız olduğunu iddia etdikləri orqanların çox mühüm funksiyaları olduğunu üzə çıxarmışdır.
Başqa sözlə, elmi irəliləyiş təkamülün dəlili kimi dəyərləndirilən xüsusiyyətlərin əslində yaradılış həqiqətinin dəlili olduğunu göstərmişdir. Təkamülçülər obyektiv hərəkət etməli və elmi kəşfləri ağılla dəyərləndirməlidirlər. “Təbiət” (Nature) jurnalında bu mövzu belə şərh edilir:
Uilson və həmkarları təkamül prosesi ərzində funksiyasını itirmiş bir orqanın qalığı kimi görünən bir əzələnin mühüm rolu olduğunu tapdı. Onların bu elmi fəaliyyəti digər rudiment orqanların da (insan appendiksi kimi) göründüyü kimi funksiyasız olub-olmadığı sualını doğurur.
Əldə edilən bu nəticələr təəccüblü deyil. Təbiətlə əlaqədar nə qədər çox şey öyrənsək, o qədər çox yaradılış dəlilini görürük. Maykl Behenin bildirdiyi kimi, “dizaynın olduğu nəticəsinə bilmədiklərimizə deyil, son 50 il boyu öyrəndiklərimizə görə gəlirik”.Buradan darvinizmin cahillikdən qaynaqlanan iddia olduğu məlum olur.
Rekapitulyasiya xətası
Bu gün Türkiyədəki bəzi təkamülçü KİV-lərdə uzun müddət əvvəl elmi ədəbiyyatdan çıxarılmış “Rekapitulyasiya” nəzəriyyəsi elmi həqiqət kimi göstərilir. Rekapitulyasiya termini təkamülçü bioloq Ernst Hekkelin XIX əsrin sonlarında ortaya atdığı “Ontogenez filogenezin təkrarıdır” (Ontogeny recapitulates phylogeny) nəzəriyyəsinin xülasəli şəkildə ifadəsidir.
Hekkel tərəfindən irəli sürülən bu nəzəriyyə canlı rüşeymlərinin inkişaf prosesi ərzində “əcdadlarının” keçirdiyi təkamül prosesini təkrarladıqlarını iddia edirdi. Məsələn, insan rüşeyminin ana bətnindəki inkişafı ərzində əvvəlcə balıq, sonra sürünən xüsusiyyətləri göstərdiyini, ən sonda insana çevrildiyini irəli sürürdü.
Halbuki sonrakı illərdə bu nəzəriyyənin tamamilə təxəyyül məhsulu olan bir ssenari olduğu məlum olmuşdur. İnsan rüşeyminin ilk dövrlərində üzə çıxdığı iddia edilən “qəlsəmələrin” əslində insanın orta qulaq kanalının, paratiroidlərinin və qalxanabənzər vəzlərinin başlanğıcı olduğu məlum olmuşdur. Rüşeymin “yumurta sarısı kisəsinə” bənzədilən hissəsinin də əslində uşaq üçün qan hazırlayan kisə olduğu aşkar edilmişdir. Hekkelin və onun davamçılarının “quyruq” adlandırdıqları hissə isə insanın onurğa sümüyüdür və ayaqlardan əvvəl meydana gəldiyi üçün “quyruq” kimi görünür.
 Ernst Hekkel çəkdiyi saxta rüşeym rəsmləri ilə elm dünyasını bir əsr boyu aldatdı.
Ernst Hekkel çəkdiyi saxta rüşeym rəsmləri ilə elm dünyasını bir əsr boyu aldatdı. |
Bunlar elm dünyasında hər kəsə məlum olan həqiqətlərdir. Təkamülçülər də bunu qəbul edirlər. Qabaqcıl darvinistlərdən olan Corc Qeylord Simpson və U.Bek “Hekkel təkamül prosesini səhv göstərib. Bu gün canlıların embrioloji inkişafının keçmişlərini əks etdirmədiyi artıq məlumdur” deyə yazırlar.
16 oktyabr, 1999-cu il tarixli “New scientist” jurnalında dərc olunmuş bir məqalədə Hekkelin Biogenetika qanunu haqqında belə deyilir:
(Hekkel) bunu Biogenetika qanunu adlandırdı və bu fikir rekapitulyasiya kimi məşhurlaşdı. Əslində Hekkelin dəyişilməz görünən qanununun qısa müddət sonra səhv olduğu aşkar oldu. Məsələn, insan rüşeyminin əsla balıqlar kimi qəlsəmələri yoxdur və heç vaxt yetkin sürünənə və ya meymuna bənzəyən inkişaf mərhələsindən keçmir.321
“American scientist”də dərc olunan bir məqalədə isə belə deyilir:
Biogenetika qanunu (Rekapitulyasiya nəzəriyyəsi) artıq tamamilə məhv olmuşdur. 1950-ci ildə dərsliklərdən çıxarılmışdır. Əslində elmi mübahisə kimi XX əsrin 20-ci illərində sonu çatmışdı.
Məsələnin daha da maraqlı cəhəti isə Ernst Hekkelin əslində ortaya atdığı Rekapitulyasiya nəzəriyyəsini dəstəkləmək üçün rəsm saxtakarlıqları etməsidir. Hekkel balıq və insan rüşeymlərini bir-birinə bənzətmək üçün saxta rəsmlər çəkmişdir. Bunun üzə çıxmasından sonra özünü müdafiə etmək üçün dediyi sözlər isə digər təkamülçülərin də buna bənzər saxtakarlıqlar etdiyini bildirməkdən ibarət idi:

Hekkelin saxta rəsmləri |
Etdiyim bu saxtakarlıq etirafından sonra özümü rüsvay olmuş və qınanmış hesab etməliyəm. Lakin mənim təsəllim budur ki, mənim kimi təqsirkar yüzlərlə həmkarımın, bir çox etibarlı müşahidəçi və məşhur bioloqun nəşr etdirdiyi ən yaxşı biologiya kitablarında, tezislərində və jurnallarında mənim kimi etdikləri saxtakarlıqlar, qeyri-düzgün məlumatlar, az-çox təhrif edilmiş rəsmlər var.
Məşhur elmi jurnal olan “Elm”in (Science) 5 sentyabr, 1997-ci il sayında Hekkelin rüşeym rəsmlərinin saxtakarlıq olduğunu açıqlayan bir məqalə dərc olundu. “Hekkelin rüşeymləri: saxtakarlıq yenidən aşkar edildi” başlıqlı məqalədə belə deyilir:
Londondakı Müqəddəs Corc Xəstəxanası Tibb Məktəbindən təkamülçü Maykl Riçardson “(Hekkelin rəsmlərinin) verdiyi təsəvvür, yəni rüşeymlərin bir-birinə çox bənzəməsi yalandır” deyir... O və həmkarları Hekkelin çəkdiyi növdəki və yaşdakı canlıların rüşeymlərini yenidən təhlil edərək və fotoşəkillərini çəkərək müqayisə etmişlər. Riçardson “Anatomiya və embriologiya” (Anatomy and embryology) jurnalında yazdığı məqalədə “rüşeymlər təəccüblü dərəcədə fərqlidirlər” deyə qeyd edir.
Hekkelin rüşeymləri oxşar göstərmək üçün bəzi orqanları qəsdən rəsmlərində göstərmədiyini və ya xəyali orqanlar əlavə etdiyini bildirən “Elm” (Science) jurnalı məqalənin ardında bu məlumatları verir:
Riçardson və qrupunun bildirdiyinə əsasən, Hekkel təkcə orqanlar əlavə etmək və ya çıxarmaqla kifayətlənməmiş, eyni zamanda müxtəlif növləri bir-birlərinə bənzər göstərmək üçün ölçüləri ilə də oynamış, bəzən rüşeymləri həqiqi ölçülərindən on dəfə fərqli göstərmişdir. Habelə Hekkel fərqləri gizlətmək üçün növlərin adını yazmamış və bircə növü sanki bütün heyvan qrupunun təmsilçisi kimi göstərmişdir. Riçardson və qrupunun bildirdiyinə görə, əslində bir-birlərinə çox yaxın olan balıq növlərinin rüşeymlərində belə görünüş və inkişaf prosesi baxımından çox böyük fərqlər var. Riçardson “Hekkelin rəsmləri biologiyadakı ən böyük saxtakarlıqlardan biridir” deyir.
 Son illərdə aparılan müşahidələr müxtəlif canlıların rüşeymlərinin Hekkelin
göstərdiyi kimi oxşar olmadığını sübut edir. Yuxarıdakı məməli, sürünən və yarasa
rüşeymləri arasındakı fərq bunun açıq nümunəsidir.
Son illərdə aparılan müşahidələr müxtəlif canlıların rüşeymlərinin Hekkelin
göstərdiyi kimi oxşar olmadığını sübut edir. Yuxarıdakı məməli, sürünən və yarasa
rüşeymləri arasındakı fərq bunun açıq nümunəsidir.
|
“Elm” (Science) jurnalındakı məqalədə Hekkelin bu məsələ ilə bağlı etiraflarının bu əsrin əvvəlindən etibarən ört-basdır edildiyindən və saxta rəsmlərinin dərs kitablarında elmi həqiqət kimi öyrədilməyə başlanmasından da belə bəhs edir:
Hekkelin etirafları rəsmlərinin 1901-ci ildə “Darvin və Darvindən sonra” (Darwin and after Darwin) adlı kitabda nəşr olunmasından sonra itdi. Rəsmlər ingiliscə biologiya dərsliklərində həddindən artıq çoxaldıdı.
Qısaca desək, Hekkelin rəsmlərinin saxtakarlıq olduğu hələ 1901-ci ildə üzə çıxmış, amma bütün elm dünyası bu rəsmlərlə bir əsr boyu aldadılmışdır.
Məşhur “Science” elmi jurnalının
5 sentyabr 1997-ci il sayında
Hekkelin rüşeym rəsmlərinin
saxta olduğunu
açıqlayan məqalə dərc
edildi. Məqalədə
rüşeymlərin əslində
bir-birlərindən cox fərqli
olduğu bildirilir.
|
|